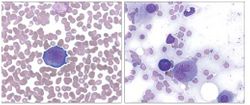

© 2025 MJH Life Sciences™ , Patient Care Online – Primary Care News and Clinical Resources. All rights reserved.
Editorial Comment: Mixing Tenofovir With Other Nephrotoxins-How Safe Is This?
Tenofovir disoproxil fumarate is extensively used for treatment of HIV infection. In addition, tenofovir has recently obtained FDA approval for treatment of hepatitis B, and it can therefore be assumed that this drug will be increasingly used in non–HIV-infected persons as well. Although the risk for nephrotoxicity with this agent is low, its widespread use will no doubt lead to more episodes of renal impairment in patients worldwide. It is important to identify those patients for whom tenofovir should not be used or, at the least, identify those patients, both HIV-infected and non–HIV-infected, for whom renal function should be more closely monitored during tenofovir use.
Tenofovir disoproxil fumarate is extensively used for treatment of HIV infection. In addition, tenofovir has recently obtained FDA approval for treatment of hepatitis B, and it can therefore be assumed that this drug will be increasingly used in non–HIV-infected persons as well. Although the risk for nephrotoxicity with this agent is low, its widespread use will no doubt lead to more episodes of renal impairment in patients worldwide. It is important to identify those patients for whom tenofovir should not be used or, at the least, identify those patients, both HIV-infected and non–HIV-infected, for whom renal function should be more closely monitored during tenofovir use.
There has been legitimate concern that renal function should be carefully monitored in tenofovir-treated patients receiving other potentially nephrotoxic drugs.1 However, cohort studies have shown that concomitant use of trimethoprim/sulfamethoxazole, when dosed for prophylaxis against opportunistic infections, is not a risk factor for renal toxicity.2 Further, one case series suggests that use of the antiviral acyclovir, NSAIDs, and cancer chemotherapeutic agents is infrequent in patients in whom tenofovir-related Fanconi syndrome develops.3 So, is it safe to mix tenofovir with other potentially nephrotoxic drugs?
Two cases reported by Psevdos and colleagues4 highlight the potential development of renal failure when using vancomycin in patients who have received tenofovir. In both cases, the patients were receiving tenofovir without evidence of renal impairment before vancomycin was initiated for osteomyelitis. Vancomycin trough levels at time of hospital discharge were relatively high so as to provide sufficient therapy for bone infections. Renal function deteriorated fairly rapidly (in both cases without evidence of Fanconi syndrome) but fortunately improved with hydration and discontinuation of the vancomycin and antiretroviral therapy.
Vancomycin-related toxicity is commonly found in patients using other concomitant nephrotoxic medications, especially aminoglycosides.5 Because the prevailing thought is that vancomycin only causes renal toxicity when other nephrotoxic drugs are used, the authors speculate that the use of tenofovir may have predisposed their 2 patients to vancomycin-related renal failure. However, recent data have suggested that the use of vancomycin by itself can cause nephrotoxicity, especially when higher vancomycin trough levels, typically over 15 µg/mL, are targeted for severe staphylococcal infections.6,7 Without an appropriate comparison group, it is impossible to determine whether tenofovir truly predisposes patients to the development of renal failure when other potentially nephrotoxic agents, such as vancomycin, are used.
So what should practitioners do if a patient is receiving tenofovir and a condition that requires another potentially nephrotoxic drug develops? And if tenofovir is used with other nephrotoxic drugs, how frequently should renal function be monitored? These important questions cannot yet be answered definitively. Further studies based on these 2 cases reported by Psevdos and colleagues are urgently required.
Samir K. Gupta, MD, MS
Assistant Professor of Medicine
Division of Infectious Diseases
Indiana University School of Medicine, Indianapolis
Dr Gupta reports the receipt of grant funding and consultant fees from Gilead Sciences, Inc, the manufacturer of tenofovir disoproxil fumarate. Dr Gupta is also the principal investigator for a phase 4 study, also sponsored by Gilead Sciences, Inc, that is investigating risk factors for antiretroviral-induced Fanconi syndrome.
References:
References1. Gupta SK, Eustace JA, Winston JA, et al. Guidelines for the management of chronic kidney disease in HIV-infected patients: recommendations of the HIV Medicine Association of the Infectious Diseases Society of America. Clin Infect Dis. 2005;40:1559-1585.
2. Gallant JE, Parish MA, Keruly JC, Moore RD. Changes in renal function associated with tenofovir disoproxil fumarate treatment, compared with nucleoside reverse-transcriptase inhibitor treatment. Clin Infect Dis. 2005;40:1194-1198.
3. Gupta SK. Tenofovir-associated Fanconi syndrome: review of the FDA adverse event reporting system. AIDS Patient Care STDS. 2008;22:99-103.
4. Psevdos G Jr, Gonzalez E, Sharp V. Acute renal failure in patients with AIDS on tenofovir while receiving prolonged vancomycin course for osteomyelitis. AIDS Reader. 2009;19:235-238.
5. Cosgrove SE, Vigliani GA, Fowler VG Jr, et al. Initial low-dose gentamicin for Staphylococcus aureus bacteremia and endocarditis is nephrotoxic. Clin Infect Dis. 2009;48:713-721.
6. Hidayat LK, Hsu DI, Quist R, et al. High-dose vancomycin therapy for methicillin-resistant Staphylococcus aureus infections: efficacy and toxicity. Arch Intern Med. 2006;166:2138-2144.
7. Lodise TP, Lomaestro B, Graves J, Drusano GL. Larger vancomycin doses (at least four grams per day) are associated with an increased incidence of nephrotoxicity. Antimicrob Agents Chemother. 2008;52:1330-1336.